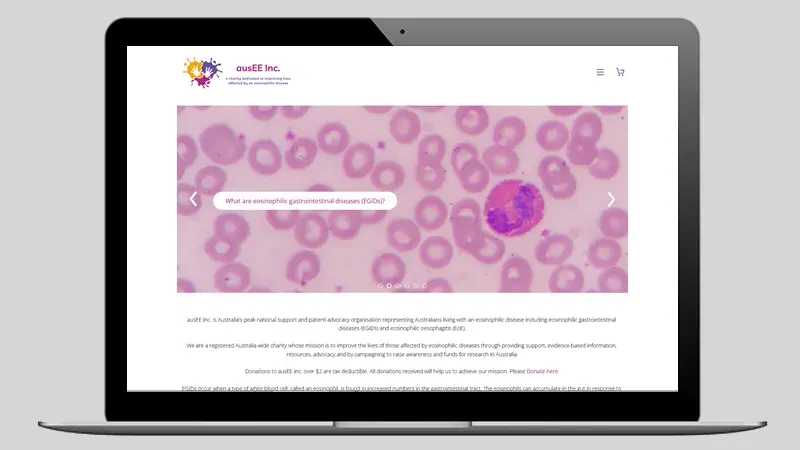

&w=3840&q=75)
- Home
- Health Professionals
- Patient Support
Patient Support
Refer your patients to best practice national support organisations, projects and resources to help them manage their food allergies.
Learn MoreAllergy & Anaphylaxis Australia
A&AA is the national support organisation dedicated to helping individuals and carers to manage food allergy and the risk of anaphylaxis
Learn MoreReporting a reaction to a food
A&AA helps patients and health professionals report reactions to packaged food or food purchased from food service providers
Learn MoreAusEE
AusEE Inc. is Australia’s peak national support and patient advocacy organisation for Australians living with an Eosinophilic Gastrointestinal disorder including Eosinophilic Oesophagitis (EoE)
Learn MoreAllergy 250K Website
Refer teens and young adults to age appropriate information, resources and support
Learn MoreNip Allergies in the Bub
Refer patients to practical, evidence-based information about how to introduce the common allergy causing foods and manage eczema
Learn MoreFood allergy education for the community
Refer your patients to easy to understand, practical information to help manage their food allergy